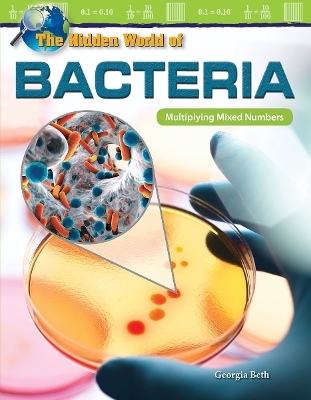
The Hidden World of Bacteria - Georgia Beth

The Hidden World of Bacteria
Multiplying Mixed Numbers
Seiten
2018
Teacher Created Materials, Inc (Verlag)
978-1-4258-5816-2 (ISBN)
Teacher Created Materials, Inc (Verlag)
978-1-4258-5816-2 (ISBN)
- Titel nicht im Sortiment
- Artikel merken
This text integrates math and literacy skills and uses real-world examples to help grade 5 students explore math in a meaningful way. Students will practice multiplying mixed numbers while engaged in reading about fascinating uses for bacteria.
Bacteria have a slimy reputation. They're too small to see with the human eye, so it's easy to let them slip past unnoticed. But, bacteria are part of our daily lives. In fact, they affect everything from milk to our moods. Get ready to zoom in on the hidden world of bacteria and explore the many ways that bacteria are being used in the modern world. This nonfiction reader seamlessly integrates the teaching of math and reading, and uses real-world examples to teach multiplication of mixed numbers. Text features include images, a glossary, an index, captions, and a table of contents to build students' vocabulary and reading comprehension skills as they interact with the text. The rigorous practice problems, math charts and diagrams, and sidebars extend learning and provide multiple opportunities for students to practice what they have learned. The Math Talk section provides an in-depth problem-solving experience.
Bacteria have a slimy reputation. They're too small to see with the human eye, so it's easy to let them slip past unnoticed. But, bacteria are part of our daily lives. In fact, they affect everything from milk to our moods. Get ready to zoom in on the hidden world of bacteria and explore the many ways that bacteria are being used in the modern world. This nonfiction reader seamlessly integrates the teaching of math and reading, and uses real-world examples to teach multiplication of mixed numbers. Text features include images, a glossary, an index, captions, and a table of contents to build students' vocabulary and reading comprehension skills as they interact with the text. The rigorous practice problems, math charts and diagrams, and sidebars extend learning and provide multiple opportunities for students to practice what they have learned. The Math Talk section provides an in-depth problem-solving experience.
| Erscheinungsdatum | 30.01.2018 |
|---|---|
| Reihe/Serie | Mathematics in the Real World |
| Zusatzinfo | full-color |
| Verlagsort | Westminster |
| Sprache | englisch |
| Maße | 178 x 229 mm |
| Gewicht | 68 g |
| Themenwelt | Kinder- / Jugendbuch ► Sachbücher ► Naturwissenschaft / Technik |
| Kinder- / Jugendbuch ► Spielen / Lernen ► Mathematik | |
| Schulbuch / Wörterbuch | |
| ISBN-10 | 1-4258-5816-3 / 1425858163 |
| ISBN-13 | 978-1-4258-5816-2 / 9781425858162 |
| Zustand | Neuware |
| Informationen gemäß Produktsicherheitsverordnung (GPSR) | |
| Haben Sie eine Frage zum Produkt? |
Mehr entdecken
aus dem Bereich
aus dem Bereich
Wie groß ist die Unendlichkeit?
Buch | Hardcover (2024)
FISCHER Sauerländer (Verlag)
CHF 25,90


